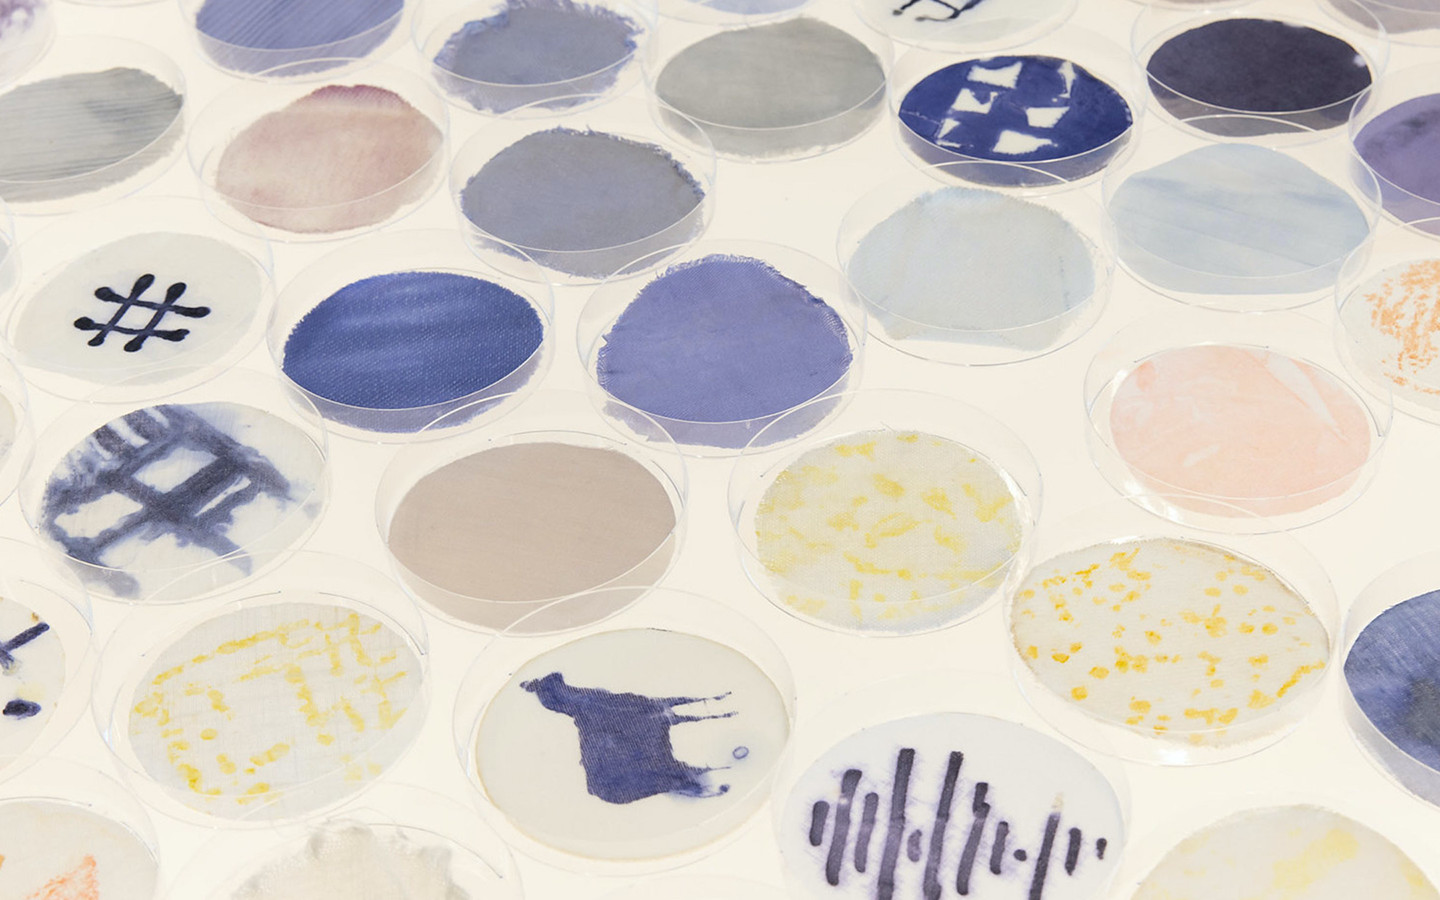
Yearning for Colour

Yearning for Colour
Living colours for a greener future
Not colouring rivers by dyeing textiles, but colouring fabrics by the waters coloured by bacteria...YEARNING FOR COLOUR uses bacteria from nature to produce sustainable pigments that require hardly any water and no harmful chemicals. As co-designers, the pigment bacteria are instrumental in finding the shape of the garments and help create unique garment shapes. Discarded fabrics from hospitals are used for dyeing to save resources, recycle and lead to more healing for nature and people.
Company/Institution
Kunstuniversität Linz
Die Kunstuniversität Linz profiliert sich künstlerisch, gestalterisch und forschend als ein Ort des unbeschränkten, mutigen und visionären Denkens sowie als kritische Experimentierzone. Sie hat den Anspruch zukunftsorientiert zu handeln und sich inhaltlich und ressourcenmäßig den sozialen, ökologischen, technologischen und gesellschaftlichen Herausforderungen von Globalisierung und Digitalisierung zu stellen, indem sie sich den Themen von zeitgenössischer und zukünftiger Kunst, postdigitaler Kulturen, nachhaltiger und kritischer Gestaltung und transformative Forschung und Bildung stellt.

Country
Austria
Website
Designer(s)
Julia Moser

Meine Arbeit ist stets von hohem Innovationsgrad geprägt, aber beschäftigt sich vor allem mit Themen der Nachhaltigkeit, Heilung und der Verbindung zur Natur. Meine Mission ist es, für mehr Bewusstsein in der Textil- und Modebranche zu sorgen. Spezielles Anliegen ist es mir, die textile Bakterienfärbung voranzutreiben und wettbewerbsfähig zu machen. Meine Arbeiten dazu wurden mehrfach ausgezeichnet, waren auf ARS Electronica Festivals, sind in permanenten Sammlungen (Design Museum Holon, ARS Electronica Center), erschien in sämtlichen Magazinen und ich gab einige Talks und Workshops dazu.